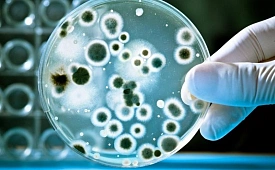

вирусы

В России стартует расширенная диспансеризация
Какие новшества ждут пациентов поликлиник в 2026 году
/ / Последнее
Автор: Дмитрий Зорин
В Японии отмечают рост случаев заражения опасной вирусной инфекцией
Уровень смертности от заболевания достигает 30%
/ / Мир
Автор: Белла Лебедева

Тройную эпидемию ждут российские врачи
Медики рассказали о том, с каким миксом вирусов мы вот-вот столкнёмся
/ / Последнее
Автор: Светлана Седова

Учёные научились по-новому уничтожать опасные вирусы
Если тесты пройдут удачно, человечество имеет шанс избавиться от герпеса
/ / Последнее
Автор: Белла Лебедева

Учёные обнаружили уникальное скопление гигантских вирусов
Ранее никто не сталкивался с такими необычными формами
/ / Разное
Автор: Белла Лебедева
